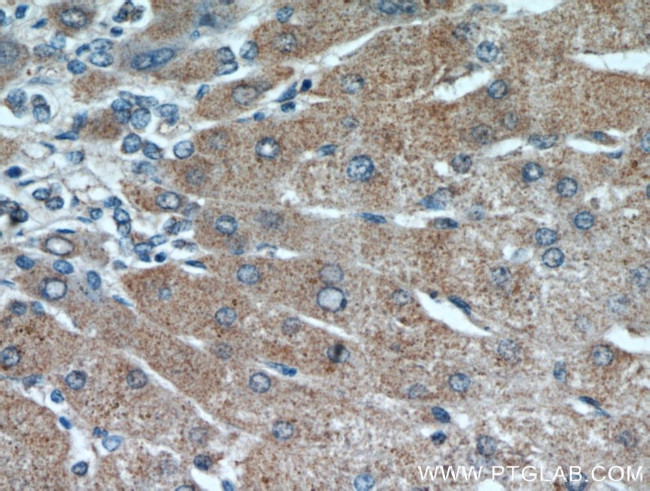
RANBP10 Antibody in Immunohistochemistry (Paraffin) (IHC (P))

Search
Proteintech
RANBP10 Polyclonal Antibody
{{$productOrderCtrl.translations['antibody.pdp.commerceCard.promotion.promotions']}}
{{$productOrderCtrl.translations['antibody.pdp.commerceCard.promotion.viewpromo']}}
{{$productOrderCtrl.translations['antibody.pdp.commerceCard.promotion.promocode']}}: {{promo.promoCode}} {{promo.promoTitle}} {{promo.promoDescription}}. {{$productOrderCtrl.translations['antibody.pdp.commerceCard.promotion.learnmore']}}
产品信息
21107-1-AP
种属反应
已发表种属
宿主/亚型
分类
类型
抗原
偶联物
形式
浓度
规格
纯化类型
保存液
内含物
保存条件
运输条件
产品详细信息
Immunogen sequence: YPGSPSLSP RHGPSSSHMH NTGADSPSCS NGVASTKSKQ NHSKYPAPSS SSSSSSSSSS SSPSSVNYSE SNSTDSTKSQ HHSSTSNQET SDSEVEMEAE HYPNGVLGSM STRIVNGAYK HEDLQTDESS MDDRHPR (362-497 aa encoded by BC099917 )
靶标信息
The RAN binding protein 10 (RANBP10) is a cytoplasmic guanine nucleotide exchange factor that shares high sequence similarity to the MET-interacting protein RANBP9. RANBP10 is expressed in the cytoplasm of mature megakaryocytes (MKs) and platelets where it localizes to polymerized noncentrosomal microtubules. RANBP10 possesses guanine nucleotide exchange factor activity towards RAN, a GTPase involved in nucleocytoplasmic traffic, spindle formation at mitosis, and nuclear envelope assembly during telophase, suggesting that RANBP10 may also be involved in these activities. RANBP10 depletion in vitro caused the disturbance of polymerized filaments in MKs and platelets in RANBP10-null mice exhibited disorders in microtubule filament numbers and localization, indicating that RANBP10 may play a significant role in maintaining microtubule dynamics.
仅用于科研。不用于诊断过程。未经明确授权不得转售。
生物信息学
蛋白别名: Ran-binding protein 10; RanBP10; rangef; unnamed protein product
基因别名: 4432417N03Rik; KIAA1464; RANBP10; RGD1311587
UniProt ID: (Human) Q6VN20, (Mouse) Q6VN19
Entrez Gene ID: (Human) 57610, (Mouse) 74334, (Rat) 361396